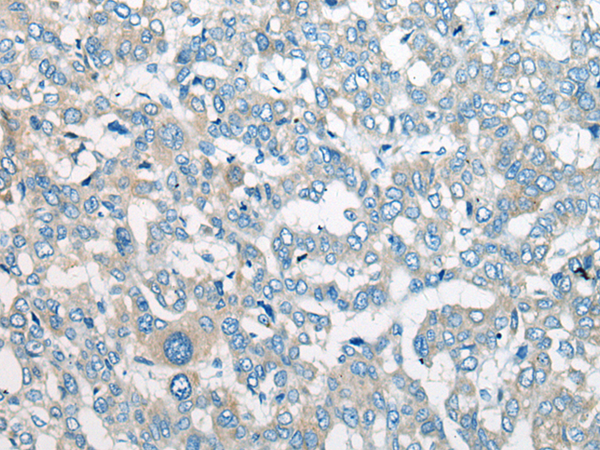

中文名稱:兔抗CEP170多克隆抗體
英文名稱: Anti-CEP170 rabbit polyclonal antibody
別 名: centrosomal protein 170; KAB; FAM68A; KIAA0470
相關(guān)類別: 一抗
儲(chǔ) 存: 冷凍(-20℃)
宿 主: Rabbit
反應(yīng)種屬: Human, Mouse
標(biāo) 記 物: Unconjugate
克隆類型: rabbit polyclonal
技術(shù)規(guī)格
|
Background: |
The product of this gene is a component of the centrosome, a non-membraneous organelle that functions as the major microtubule-organizing center in animal cells. During interphase, the encoded protein localizes to the sub-distal appendages of mature centrioles, which are microtubule-based structures thought to help organize centrosomes. During mitosis, the protein associates with spindle microtubules near the centrosomes. The protein interacts with and is phosphorylated by polo-like kinase 1, and functions in maintaining microtubule organization and cell morphology. The human genome contains a putative transcribed pseudogene. Several alternatively spliced transcript variants of this gene have been found, but the full-length nature of some of these variants has not been determined. |
|
Applications: |
ELISA, WB, IHC |
|
Name of antibody: |
CEP170 |
|
Immunogen: |
Synthetic peptide of human CEP170 |
|
Full name: |
centrosomal protein 170 |
|
Synonyms: |
KAB; FAM68A; KIAA0470 |
|
SwissProt: |
Q5SW79 |
|
ELISA Recommended dilution: |
5000-10000 |
|
IHC positive control: |
Human liver cancer |
|
IHC Recommend dilution: |
10-50 |
|
WB Predicted band size: |
175 kDa |
|
WB Positive control: |
PC-3 cell lysate |
|
WB Recommended dilution: |
200-1000 |

購(gòu)物車
幫助
021-54845833/15800441009
